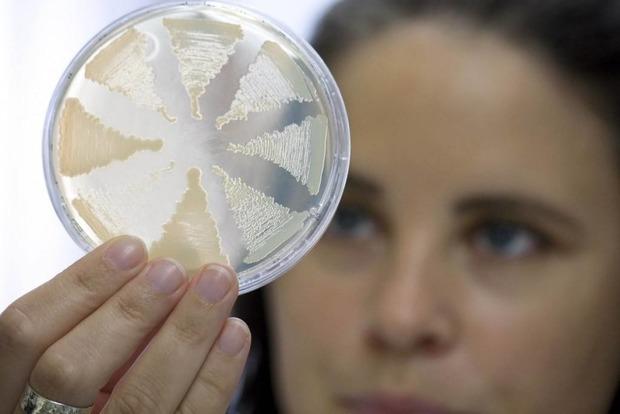
Ботулізм на Донеччині: захворіли 2 дорослих та 1 дитина

У Донецькій області зареєстрували три випадки ботулізму. Серед хворих двоє дорослих та одна дитина.
Про це повідомляє департамент охорони здоров’я Донецької обласної державної адміністрації.
Дорослі знаходяться в реанімаційних відділеннях лікарень, їм ввели сироватки. При цьому їх стан залишається важким. Про перебіг захворювання у дитини не повідомляється.
«У серпні 2018 року Україна отримала 12 доз протиботулістичної сироватки на 24 області, 3 з яких на данному етапі вже використані жителями Донецької області», — йдеться у повідомленні.
Нагадаємо, у травні 2018 року Міністерство охорони здоров’я провело закупівлю вакцини від ботулізму. Придбати її за кошти держбюджету вирішили через відсутність її у деяких регіонах. Раніше сироватки мали закуповувати за кошти місцевих бюджетів.
Може бути цікаво


Удар по демінерах норвезької організації на Херсонщині: кількість загиблих зросла до двох

Скандал довкола полку «Скеля»: ми поспілкувалися з його представником і авторкою розслідування. І ось що дізнались